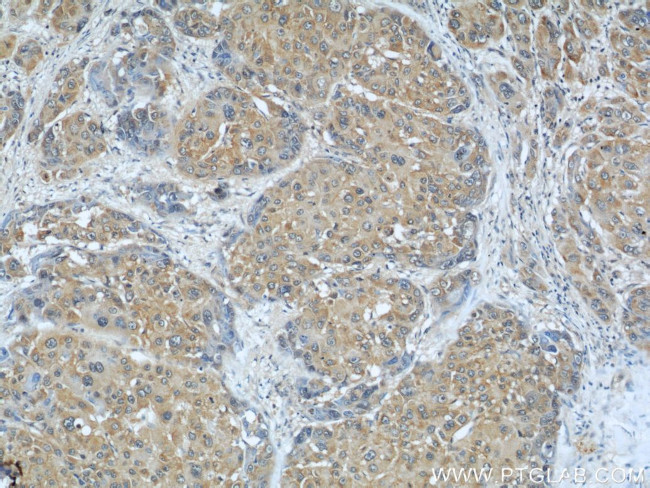
AIP/ARA9 Antibody in Immunohistochemistry (Paraffin) (IHC (P))

Search
Proteintech
AIP/ARA9 Polyclonal Antibody
{{$productOrderCtrl.translations['antibody.pdp.commerceCard.promotion.promotions']}}
{{$productOrderCtrl.translations['antibody.pdp.commerceCard.promotion.viewpromo']}}
{{$productOrderCtrl.translations['antibody.pdp.commerceCard.promotion.promocode']}}: {{promo.promoCode}} {{promo.promoTitle}} {{promo.promoDescription}}. {{$productOrderCtrl.translations['antibody.pdp.commerceCard.promotion.learnmore']}}
产品信息
18176-1-AP
种属反应
宿主/亚型
分类
类型
抗原
偶联物
形式
浓度
规格
纯化类型
保存液
内含物
保存条件
运输条件
产品详细信息
Immunogen sequence: MADIIARLR EDGIQKRVIQ EGRGELPDFQ DGTKATFHYR TLHSDDEGTV LDDSRARGKP MELIIGKKFK LPVWETIVCT MREGEIAQFL CDIKHVVLYP LVAKSLRNIA VGKDPLEGQR HCCGVAQMRE HSSLGHADLD ALQQNPQPLI FHMEMLKVES PGTYQQDPWA MTDEEKAKAV PLIHQEGNRL YREGHVKEAA AKYYDAIACL KNLQMKEQPG SPEWIQLDKQ ITPLLLNYCQ CKLVVEEYYE VLDHCSSILN KYDDNVKAYF KRGKAHAAVW NAQEAQADFA KVLELDPALA PVVSRELRAL EARIRQKDEE DKARFRGIFS H (1-330 aa encoded by BC104797)
靶标信息
The protein encoded by this gene is a receptor for aryl hydrocarbons and a ligand-activated transcription factor. The encoded protein is found in the cytoplasm as part of a multiprotein complex, but upon binding of ligand is transported to the nucleus. This protein can regulate the expression of many xenobiotic metabolizing enzymes. Also, the encoded protein can bind specifically to and inhibit the activity of hepatitis B virus.
仅用于科研。不用于诊断过程。未经明确授权不得转售。
生物信息学
蛋白别名: Ah receptor activated 9; AH receptor-interacting protein; AIP; aryl hydrocarbon receptor interacting protein; aryl hydrocarbon receptor-associated protein 9; Aryl-hydrocarbon receptor-interacting protein; FK506-binding protein 37; FKBP prolyl isomerase 16; HBV X-associated protein 2; HBV-X associated protein; hepatitis B virus X-associated cellular protein 2; Immunophilin homolog ARA9; Immunophilin XAP2; X-associated protein-2; XAP-2
基因别名: AA408703; AIP; ARA9; AW476050; D19Bwg1412e; FKBP16; FKBP37; PITA1; SMTPHN; XAP-2; XAP2
UniProt ID: (Human) O00170, (Mouse) O08915, (Rat) Q5FWY5
Entrez Gene ID: (Human) 9049, (Mouse) 11632, (Rat) 282827